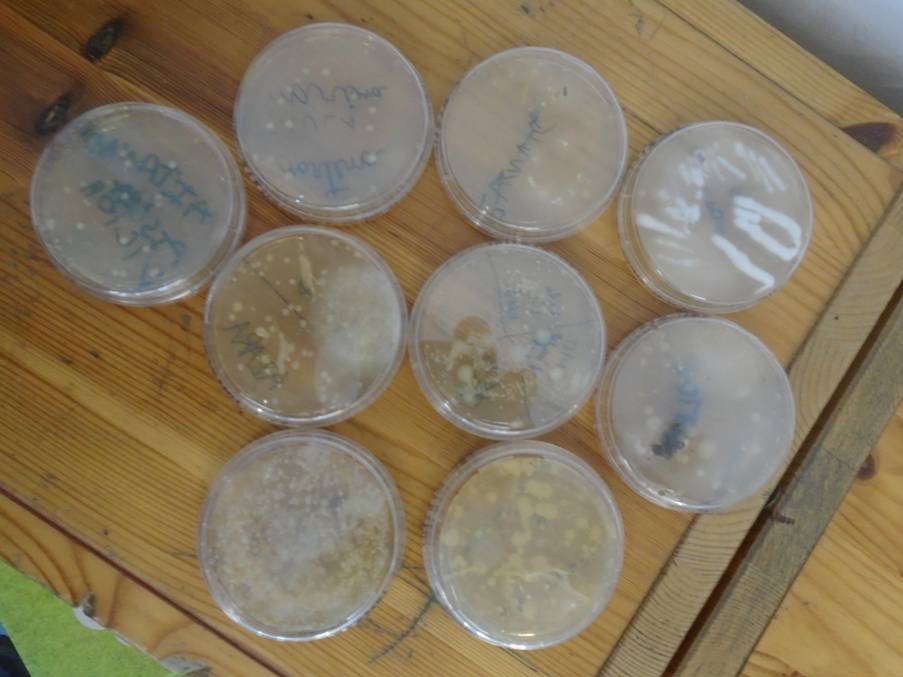

La Núria mama de l’Aitana treballa a un laboratori. És experta en fongs i ens va respondre algunes preguntes que teníem sobre els fongs de laboratori.
Ens va ensenyar a sembrar fongs . 
Ens va donar plaques de petri netes amb 2 tipus de gelatina, una on hi poden créixer només fongs i una on hi poden créixer fongs i altres microorganismes. Per parelles vam decidir amb què la fregaríem: per la pissarra, les mans , la taula i el terra.
Ho hem deixat reposar fins el dilluns i alguns tenien taques i alguns estaven tots plens de fongs i altres de fongs i microorganismes.
Plaques amb fongs i altres microorganismes
Ens va ajudar a entendre més coses sobre els fongs i a saber perquè al laboratori tenen fongs.

Moltes gràcies per convidar-me a explicar coses dels fongs. Sou uns nens i nenes increíbles
Núria, moltes gràcies per vindre a explicar-nos coses sobre fongs i per portar-nos les plaques de Petri i plaques amb fongs. Ens han crescut molts fongs i altres microorganismes.